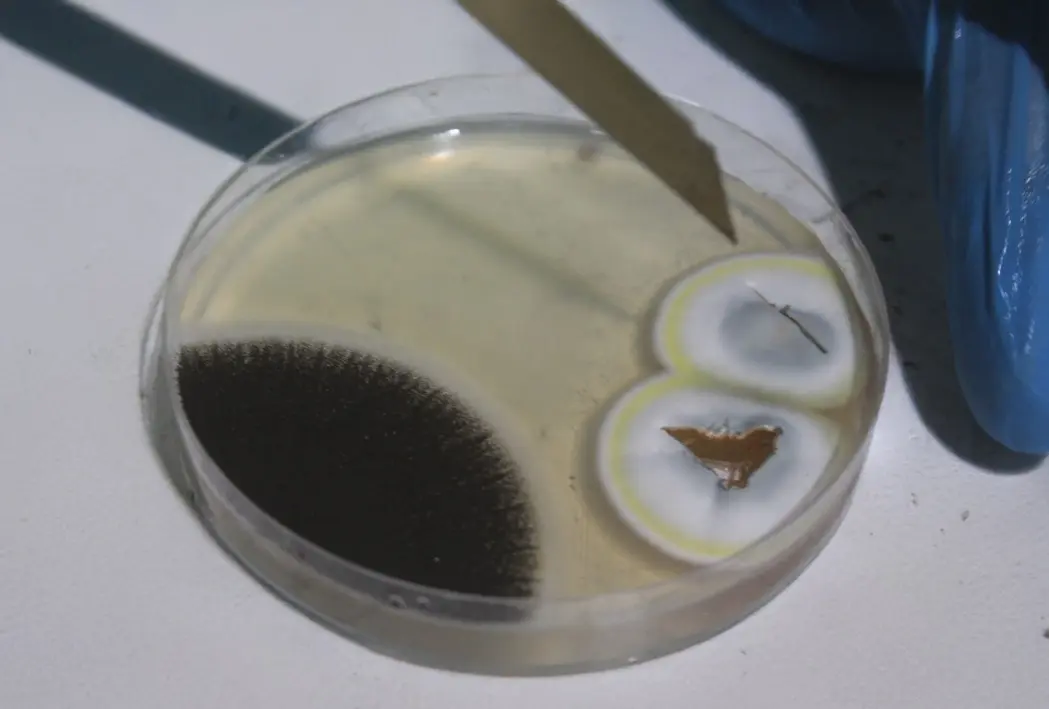

MANTAR (FUNGUS) TESTİ
Mantar Testi (Fungus Testi)
Standart Kontrol ve Test Hizmetleri A.Ş. olarak, askeri ve sivil sektörlerde çevresel test hizmeti sağlayıcısı olarak, ürünlerinizin mantar ve küf üremesine karşı dayanıklılığını detaylı bir şekilde değerlendirmek için kapsamlı Mantar Testi (Fungus Testi) hizmeti sunmaktayız. Bu testler, ürünlerinizin çeşitli ortamlarda nasıl performans gösterdiğini belirlemek ve potansiyel mantar büyümesinin ürün işlevselliği üzerindeki etkilerini değerlendirmek açısından kritik öneme sahiptir.
Standartlar ve Yaklaşım Kapsam
- Mantar Testi süreçlerimiz, askeri uygulamalar için çevresel test yöntemlerini içeren MIL-STD-810 standartları doğrultusunda yürütülür.
- Havacılık endüstrisi için güvenilirlik ve dayanıklılık gereksinimlerini içeren RTCA DO-160 G standardı dikkate alınır.
- Bu yaklaşım, ürünlerinizin özellikle askeri ve havacılık uygulamalarında güvenilirlik standartlarına uygunluğunu destekler.
Sağlanan Katkı Değer
- Testler sırasında elde edilen veriler; ürün tasarımınızı optimize etmek ve üretim süreçlerinizi iyileştirmek amacıyla kullanılabilir.
- Mantar ve küfün ürün işlevselliği üzerindeki potansiyel etkileri değerlendirilerek risklere karşı proaktif bir yaklaşım sağlanır.
- Çevresel koşullara karşı dayanımın doğrulanması, ürünlerinizin pazardaki rekabet avantajını ve müşteri memnuniyetini artırmaya katkı sağlar.
Uzmanlık ve Uygulama Ekip
- Uzman ekibimiz, yüksek kalite standartlarına uygun şekilde Mantar Testi hizmetlerini yürütür.
- Sektöre özgü ve kapsamlı test yaklaşımımız ile ürünlerinizin çevresel koşullara karşı üst düzey dayanıklılığını destekleriz.
- Güvenilir, kapsamlı ve standarda uygun test çıktıları ile ürün doğrulama süreçlerinize katkı sağlarız.
Mantar Testinin Önemi Risk
- Mantar ve küf oluşumu; malzeme bozulması, izolasyon zayıflaması ve performans kaybı gibi riskler doğurabilir.
- Bu test, ürünlerinizin kullanım senaryolarında oluşabilecek biyolojik risklere karşı dayanımını doğrulamayı hedefler.
STEST olarak, MIL-STD-810 ve RTCA DO-160 G doğrultusunda Mantar Testi (Fungus Testi) süreçlerini uyguluyor; ürünlerinizin biyolojik etkiler kaynaklı risklere karşı dayanımını doğrulamak için kapsamlı raporlama sunuyoruz.
TEST RANDEVU TALEBİ OLUŞTUR